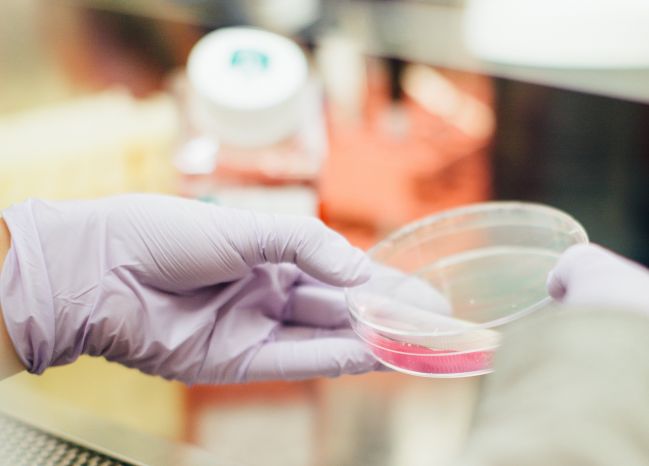
showcase image

Supporting a review of West Midlands community dental services
As part of a review of community dental services, NHS Arden & GEM’s engagement and communications specialists were commissioned to design and deliver a comprehensive patient and public engagement study.
Establishing a High Consequence Infectious Disease (HCID) service
Through a successful collaboration with NHS England Specialised Commissioning, Arden & GEM’s award winning procurement team developed and delivered a process which will ensure the public is protected in the event of HCIDs through a high quality, family centred and value for money service.
Procuring GP services in Staffordshire
Arden & GEM’s primary care procurement specialists worked in collaboration with NHS England North Midlands, Cannock Chase CCG and South East Staffordshire and Seisdon Peninsula CCG, to run a complex procurement process to appoint three providers to deliver high quality, patient centred, value...
Raising awareness of modern slavery in the West Midlands
In order to raise awareness of the prevalence of modern slavery in the West Midlands, and the devastating effects it can have on health, Arden & GEM brought together key agencies and organisations (including the NHS, West Midlands Police, Birmingham City Council and the West Midlands Anti Sla...
Improving prescribing practice in primary care
When NHS South Warwickshire Clinical Commissioning Group (CCG) identified an 11% overspend on prescribing budget in one of their GP practices, the Arden & GEM medicines optimisation team was tasked with investigating the potential causes and producing a report for the CCG.
Decision support solution for Mid-Nottinghamshire CCGs
With challenging financial objectives facing Mansfield and Ashfield, and Newark and Sherwood Clinical Commissioning Groups (CCGs), the senior team needed a current analysis of cost control options and QIPP opportunities to inform robust decision making. NHS Arden & GEM Commissioning Support U...
Developing a place-based digital maturity assessment
In order to support local health and care systems develop digital strategies which deliver improved patient care and outcomes, NHS England commissioned a programme of work to develop an assessment method. Led by NHS Arden & GEM CSU, Oxfordshire AHSN, and Greater Manchester AHSN, the 12 month...
Harmonising treatment policies in Birmingham, Sandwell and Solihull
Arden & GEM managed and delivered an 18 month project, on behalf of NHS Birmingham and Solihull CCG and NHS Sandwell and West Birmingham CCG, to develop 22 harmonised policies, ready for implementation in January 2019. The new policies will ensure the best clinical outcomes are achieved for p...
Establishing the Global Digital Exemplar Learning Network
To support the GDE programme in sharing learning and experiences to accelerate digital transformation, NHS Arden & GEM CSU was commissioned to establish, lead and facilitate a GDE Learning Network.
Developing a clinical registry and outcomes system for hepatitis C
Arden & GEM’s business intelligence team developed a hepatitis C patient registry and treatment outcome system to improve the quality of data analysis to enable effective expenditure planning, inform the creation of new clinical service models and to maximise effectiveness of treatment.